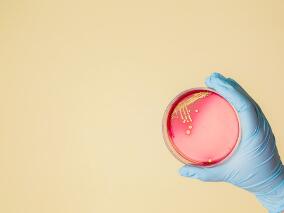
引起新生儿迟发性菌血症的凝固酶阴性葡萄球菌难对付?头孢唑林或能降服

-
艾滋感染者戒烟困难 或因抗逆转录病毒治疗作祟
环球医学资讯
2021年12月30日
点击量:230
1小时条评论因抗逆转录病毒治疗(ART)的出现,人类免疫缺陷病毒(HIV)感染者从致命性疾病变成慢性病。然而,HIV感染者另外的一个大问题是吸烟。有研究显示,北美地区接受艾滋病治疗的人群,五分之一的癌症是吸烟所致。而对于每天要抽上一包烟的HIV感染者来说,戒烟难,难于上...
-
艾滋感染者:换药多替拉韦前未检测病毒载量 治疗失…
环球医学资讯
2021年12月28日
点击量:462
1小时条评论世界卫生组织(WHO)指南建议,将多替拉韦作为艾滋病毒(HIV)感染者首选的抗逆转录病毒治疗(ART)方案,且在全球推广;如果已经在服用其他ART,换药为含多替拉韦方案之前,需检测病毒载量(VL)。然而,因为种种现实的原因,并不是人人都进行了该检测。 2021年12...
-
念珠菌血症和或/侵袭性念珠菌病:瑞扎芬净vs卡泊芬净
环球医学资讯
2021年12月27日
点击量:660
1小时条评论侵袭性念珠菌病(IC)仍然是发病和死亡的重要原因。尽管在过去20年中抗真菌治疗取得了重大进展,但死亡率仍保持在30%~60%。2021年12月,美国、西班牙、希腊等国学者发表在《Clin Infect Dis》的STRIVE试验,探究了瑞扎芬净(RZF)vs卡泊芬净(CAS)治疗念珠菌血症和...
-
基于贝达喹啉的疗法用于耐药结核病 有效性和心脏安…
环球医学资讯
2021年12月27日
点击量:421
1小时条评论耐药结核病仍然是重大的公共卫生威胁,并破坏了全世界对结核病的控制。2021年12月,美国和南非学者发表在《Clin Infect Dis》的一项前瞻性队列研究,探究了基于贝达喹啉的疗法对于耐药结核病的有效性和心脏安全性。 背景:贝达喹啉可改善利福平耐药(RR)结核病患者...
-
艾滋感染者不愿接种新冠疫苗 在担忧什么?这项中国…
环球医学资讯
2021年12月23日
点击量:283
1小时条评论新冠疫情来袭,艾滋病毒(HIV)感染者一方面因免疫力受损,更易于感染新冠,理应更快接种COVID-19疫苗;另一方面又因种种担忧,可能犹豫不决甚至拒绝接种疫苗。那么,这些HIV感染者究竟在担心什么呢? 2021年12月,中国和澳大利亚学者发表在《Hum Vaccin Immunother...
-
艾滋感染者每天坚持吃药有挑战?两个月用1次药的方…
环球医学资讯
2021年12月21日
点击量:812
1小时条评论30多年前,抗逆转录病毒疗法(ART)首次获批,HIV从致命性疾病变为类似于高血压的慢性疾病。然而,ART需每日用药,保持良好依从性是个挑战,并进而影响了疗效。 2021年11月,在《Lancet HIV》上的ATLAS-2M研究96周分析结果显示,每月或每2月给药长效卡替拉韦和利匹...
-
基于蛋白酶抑制剂的DAA增加转氨酶升高风险 但是…
环球医学资讯
2021年12月14日
点击量:189
1小时条评论2021年12月,发表在《J Hepatol》的一项研究显示,基于蛋白酶抑制剂的直接作用抗病毒药物与转氨酶升高的风险增加有关,但与肝功能障碍或肝失代偿无关。 背景与目的:在接受基于蛋白酶抑制剂(PI)的直接作用抗病毒药物(DAA)方案治疗的慢性HCV感染患者中,已报...
-
引起新生儿迟发性菌血症的凝固酶阴性葡萄球菌难对付…
环球医学资讯
2021年12月02日
点击量:206
1小时条评论凝固酶阴性葡萄球菌(CoNS)原是皮肤、口腔及肠道的正常菌群之一,但随着多重耐药菌株的出现,其已成为主要的致病菌之一。最近从新生儿重症监护病房(NICUs)发现的克隆头状葡萄球菌分离株NRCS-A,对万古霉素耐药,想要清除该克隆具有挑战。2021年11月,澳大利亚学者...
-
治疗直肠衣原体感染:多西环素vs阿奇霉素
环球医学资讯
2021年12月02日
点击量:807
1小时条评论沙眼衣原体感染是最常见的性传播疾病,据2019年数据,美国每年报告的病例超过180万例,患病率为552.8例/10万人。2021年11月,中国学者发表在《J Antimicrob Chemother》的一项系统评价和Meta分析,探究了多西环素vs阿奇霉素治疗直肠衣原体的有效性。 背景:沙眼衣原...
-
一文了解术后腹膜炎管理中治疗失败的风险因素
环球医学资讯
2021年12月02日
点击量:184
1小时条评论治疗失败是腹腔感染管理中的常见问题。在术后腹膜炎中,这种并发症可导致以器官功能障碍和复杂的来源控制为特征的危及生命的问题。2021年11月,法国学者发表在《J Antimicrob Chemother》的DURAPOP试验的事后分析,调查了术后腹膜炎管理中治疗失败的风险因素。 背景...

会员登录

